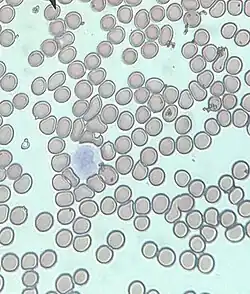

Hematologia
![]() Células sanguíneas de anfíbios | |
| Sistema | Atendimentos clinicos |
|---|---|
| Foco | Estudo de doenças relacionadas ao sangue |
| Doenças significativas | leucemia, linfoma, hemoglobinopatia... |
Hematologia é o ramo da biologia e especialidade clínica que estuda o sangue dos demais animais com sistema circulatório fechado. A palavra é composta pelos radicais gregos: Haima (de haimatos), "sangue" e lógos, "estudo, tratado, discurso".[1][2]
A hematologia estuda, principalmente, os elementos figurados do sangue: hemácias (glóbulos vermelhos), leucócitos (glóbulos brancos) e plaquetas. Estuda, também, a produção desses elementos e os órgãos onde eles são produzidos (órgãos hematopoiéticos): medula óssea, baço e linfonodos.[3][4]
Além de estudar o estado de normalidade dos elementos sanguíneos e dos órgãos hematopoiéticos, estuda as doenças a eles relacionadas.
Hematologia humana
A especialidade médica responsável por essa área é a da hematologia e hemoterapia. Médicos especializados em hematologia são conhecidos como hematologistas. O trabalho de rotina inclui principalmente o cuidado e o tratamento de pacientes com doenças hematológicas, embora alguns podem também trabalhar no laboratório de hematologia com a visualização de laminas de sangue e de medula óssea sob o microscópio , interpretando vários resultados de testes hematológicos. Hematologia é uma sub-especialidade da clinica médica muito ligada com a oncologia, tratando doenças como leucemia e linfoma. Hematologistas podem se especializar ainda mais ou têm interesses especiais, por exemplo, em:[5][3]
- o tratamento de distúrbios hemorrágicos, tais como a hemofilia e púrpura trombocitopênica idiopática
- tratamento de malignidades hematológicas, tais como linfoma e de leucemia
- tratamento de hemoglobinopatias
- ciência da transfusão de sangue e o trabalho de um banco de sangue
- medula óssea e transplante de células tronco
No Brasil , para se tornar um médico hematologista é necessário , após a faculdade, fazer 2 anos de especialização em clinica médica. Após isso é necessário fazer mais um processo seletivo de acesso a especialidade de hematologia e hemoterapia, com duração de mais 2 anos, totalizando assim ao menos 10 anos de formação em tempo integral e dedicação exclusiva. Após esse tempo o médico hematologista ainda poderá fazer mais 1 ano em alguma área relacionada como por exemplo transplante de medula óssea.[1]
Doenças hematológicas
Algumas doenças hematológicas incluem:[6]
- Anemias:
- Hemoglobinopatias:
- doença falciforme
- talassemias
- hemoglobinopatia C
- hemoglobinopatia SC, entre outras.
- Coagulopatias:
- Doenças hematológicas clonais:
Exames laboratoriais
Exames utilizados na investigação hematológica incluem:
- Hemograma
- Mielograma
- Velocidade de hemossedimentação (VHS)
- Tempo de tromboplastina parcial ativada (TTPA)
- Tempo de protrombina
- Fibrinogênio
- Dímeros-D
- dosagens de fatores de coagulação, entre outros.
Referências
- ↑ a b McKenzie, Shirlyn (1988). Textbook of Hematology. [S.l.: s.n.]
- ↑ Disner, Elton. «Hematologia clínica». Clínica Soma. Consultado em 30 de novembro de 2021
- ↑ a b M., Schmidt, Robert (1979). Hematology. [S.l.]: CRC Press. OCLC 5640075
- ↑ Munker, Reinhold. «Infections Relevant to Hematology». Totowa, NJ: Humana Press: 315–325. Consultado em 30 de novembro de 2021
- ↑ «Hematologia - O que é hematologia clínica e laboratorial». www.rededorsaoluiz.com.br. Consultado em 30 de novembro de 2021
- ↑ «O que é a Hematologia?». IHHT
_Amphibian.jpg)